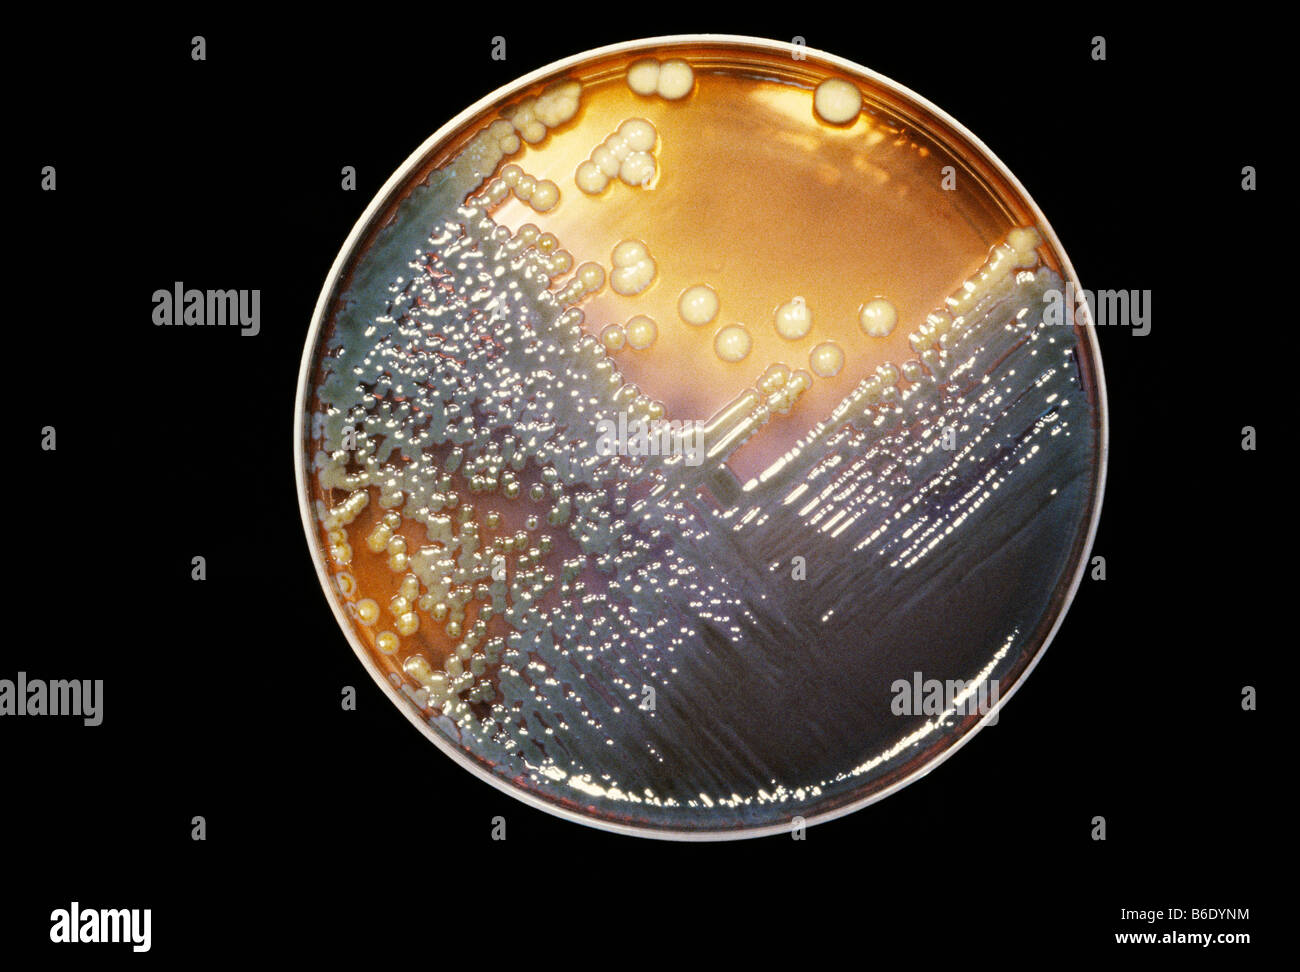
😂 What is being cultured. Cultured Synonyms, Cultured Antonyms. 2019-02-23

A garden of roses is a spectacular White Cultured Marble Countertops - emetdesign, with many varieties to choose from. One of the best things about this flower is looking for White Cultured Marble Countertops - emetdesign you've came to the right web. We have 35 Pics about White Cultured Marble Countertops - emetdesign like First-Ever Cultured Meat Factory Opens In Israel - The Planet Voice, I'm Cultured T-Shirt | SnorgTees and also Cultured (@CulturedCafeLB) | Twitter. Read more:
White Cultured Marble Countertops - Emetdesign
 emetdesign.blogspot.com
emetdesign.blogspot.com cultured schillings
Cultured - Shirtoid
 shirtoid.com
shirtoid.com cultured shirtoid shirt woot
Cultured Meat – Oct 27 – Wonderfest – Bay Area Beacon Of Science
 wonderfest.org
wonderfest.org cultured wonderfest
Cleaning Faux Or Cultured Marble? | ThriftyFun
 www.thriftyfun.com
www.thriftyfun.com marble cultured cleaning faux sink
Report Identifies Top Five Global Cultured Meat Companies
 www.newfoodmagazine.com
www.newfoodmagazine.com cultured cultivated laboratorijsko pridelano meso identifies veganuary dokler rastlinska alternativa mesni bolj tehnologija napredovala prehrambena ustvarila izdelki še bodo boljša
Multiplicity Of Infection
infection multiplicity virus cells cultured virology question week moi matters concentration ws
I'm Cultured T-Shirt | SnorgTees
 www.snorgtees.com
www.snorgtees.com cultured jokes microbiology science biology snorgtees funny puns humor visit
First-Ever Cultured Meat Factory Opens In Israel - The Planet Voice
 theplanetvoice.com
theplanetvoice.com cultured
😂 What Is Being Cultured. Cultured Synonyms, Cultured Antonyms. 2019-02-23
webstreaming.com.br
webstreaming.com.br cultured being enterobacter alamy colonies bacteria petri someone makes
Cultured Meat Will Cost Startups $150m-$370m (and Take At Least 4 More
 agfundernews.com
agfundernews.com cultured meat cost
Cultured * HAAS BROTHERS
cultured policy
Cultured Stone - The Cultured Stoners
stone cultured exteriors
Cultured * HAAS BROTHERS
cultured
Cultured Stone Fireplaces - The Cultured Stoners
stone cultured fireplaces fireplace call front
Cultured Marble Shower Base - Clickflydesigns
 clickflydesigns.blogspot.com
clickflydesigns.blogspot.com cultured surround kohler whitewater
St. Louis Cultured Marble Countertops | Lifestyle Kitchens & Baths
marble cultured countertops stains susceptible note please
Cultured Marble: An Affordable Way To Upgrade | Visual Remodeling Blog
marble cultured vanity bathroom tops piece countertops creations capital mj molded sink upgrade affordable way sinks inc choose
Food Business Africa | Cultured Decadence Secures Funding To Accelerate
 www.foodbusinessafrica.com
www.foodbusinessafrica.com decadence secures
Cultured * HAAS BROTHERS
Cultured Marble | Wolf Home Products
 www.wolfhomeproducts.com
www.wolfhomeproducts.com marble cultured vanity tops bathroom wolf countertop custom sink countertops bathrooms wolfhomeproducts counter modern options visit choose shower vanities
To Look Cultured : Therewasanattempt
 www.reddit.com
www.reddit.com cultured therewasanattempt
Being Cultured - Imprint Academic
 www.imprint.co.uk
www.imprint.co.uk cultured being imprint defence discrimination academic africanah
Culture | Project 54
 stangomj.wordpress.com
stangomj.wordpress.com Blog – Small And Backyard Poultry
 poultry.extension.org
poultry.extension.org cultured viande vitro kultiviertes cell developed usda fad pipette assiettes lilkin depositphotos cellular simplyscience foodsafetynews
Cured And Cultured Bar @ Bennelong, Sydney Opera House
 www.chocolatesuze.com
www.chocolatesuze.com bennelong sydney cured cultured opera bar
Cultured Marble Onyx & Granite Products San Diego
 www.calcraftedmarble.com
www.calcraftedmarble.com cultured onyx diyhous
Cultured - Bulatlat
 www.bulatlat.com
www.bulatlat.com cultured bulatlat dee ayroso philippine teens martin culture arts june
THE HUMAN INFLUENCE: Cultured Meat: Think Of The Possibilities
 my-environmental-stance.blogspot.com
my-environmental-stance.blogspot.com meat cultured cloned production culture possibilities produced meet creating stuff difference between animal influence human works alchetron ethical
Lab Grown/Cultured/Clean/Artificial Meat Production Business
cultured
Cultured Stone Country Ledgestone Echo Ridge – Manufactured Stone Supply
 manufacturedstonesupply.com
manufacturedstonesupply.com stone cultured ridge echo country ledgestone ledge manufactured veneer wheaton choose coral rock coronado
Cultured Vegetables Using A Starter Culture - Cultured Food Life
 www.culturedfoodlife.com
www.culturedfoodlife.com cultured vegetables culture starter using super donna check orangeade charging cutting edge fermented
Cultured Meat Debuts At Singapore Restaurant | LIVEKINDLY
 www.livekindly.co
www.livekindly.co cultured grist debuts cultivated livekindly folks
Cultured (@CulturedCafeLB) | Twitter
 twitter.com
twitter.com cultured
Dickinson Diamond Co. | Cultured Pearls
pearls cultured sorting polished ready
Cultured "art" : Animemes
 www.reddit.com
www.reddit.com cultured animemes
Cultured (@culturedcafelb). Multiplicity of infection. Report identifies top five global cultured meat companies
if you are looking "id":407,"keyword_id":14,"name":"Cultured","scraped_at":"2022-12-10 03:01:21","created_at":"2022-12-10T03:01:21.000000Z","updated_at":"2022-12-10T03:01:21.000000Z","images":["id":13735,"keyword_id":407,"url":"https:\/\/theplanetvoice.com\/wp-content\/uploads\/2021\/07\/cultured-meat-1920x1280.jpg","link":"https:\/\/theplanetvoice.com\/first-ever-cultured-meat-factory-opens-israel\/","title":"First-Ever Cultured Meat Factory Opens In Israel - The Planet Voice","thumbnail":"https:\/\/tse2.mm.bing.net\/th?id=OIP.-Y7Nd3_qUaq-jCShfdYOfwHaE8&pid=15.1","size":"1920 x 1280 \u00b7 jpeg","desc":"cultured","filetype":"jpg","width":1920,"height":1280,"domain":"theplanetvoice.com","created_at":null,"updated_at":null, SnorgTees","thumbnail":"https:\/\/tse1.mm.bing.net\/th?id=OIP.WwmOiz3nYKU95ddAVuVLhAHaHa&pid=15.1","size":"1000 x 1000 \u00b7 png","desc":"cultured jokes microbiology science biology snorgtees funny puns humor visit","filetype":"png","width":1000,"height":1000,"domain":"www.snorgtees.com","created_at":null,"updated_at":null,"id":13737,"keyword_id":407,"url":"https:\/\/www.newfoodmagazine.com\/wp-content\/uploads\/cultured-meat-image_for-web.jpg","link":"https:\/\/www.newfoodmagazine.com\/article\/120089\/report-identifies-top-five-cultured-meat-companies\/","title":"Report identifies top five global cultured meat companies","thumbnail":"https:\/\/tse4.mm.bing.net\/th?id=OIP.uSeUURWBZZ7ach3aXCEblQHaE8&pid=15.1","size":"750 x 500 \u00b7 jpeg","desc":"cultured cultivated laboratorijsko pridelano meso identifies veganuary dokler rastlinska alternativa mesni bolj tehnologija napredovala prehrambena ustvarila izdelki \u0161e bodo bolj\u0161a","filetype":"jpg","width":750,"height":500,"domain":"www.newfoodmagazine.com","created_at":null,"updated_at":null,"id":13738,"keyword_id":407,"url":"http:\/\/meticulousbplans.com\/wp-content\/uploads\/2019\/08\/Cultured-Meat.jpg","link":"https:\/\/meticulousbplans.com\/2019\/08\/19\/lab-grown-cultured-clean-artificial-meat-production-business\/","title":"Lab grown\/Cultured\/Clean\/Artificial Meat Production Business","thumbnail":"https:\/\/tse4.mm.bing.net\/th?id=OIP.8JmCOmHGqOsl75OhMU63KQHaE8&pid=15.1","size":"2000 x 1335 \u00b7 jpeg","desc":"cultured","filetype":"jpg","width":2000,"height":1335,"domain":"meticulousbplans.com","created_at":null,"updated_at":null,"id":13739,"keyword_id":407,"url":"https:\/\/manufacturedstonesupply.com\/wp-content\/uploads\/2020\/10\/cultured-stone-country-ledgestone-echo-ridge.jpg?x20366","link":"https:\/\/manufacturedstonesupply.com\/product\/cultured-stone-country-ledgestone-echo-ridge\/","title":"Cultured Stone Country Ledgestone Echo Ridge \u2013 Manufactured Stone Supply","thumbnail":"https:\/\/tse1.mm.bing.net\/th?id=OIP.5MUsnH3ao5lNijNey9V8LwHaHa&pid=15.1","size":"575 x 575 \u00b7 jpeg","desc":"stone cultured ridge echo country ledgestone ledge manufactured veneer wheaton choose coral rock coronado","filetype":"jpg","width":575,"height":575,"domain":"manufacturedstonesupply.com","created_at":null,"updated_at":null,"id":13740,"keyword_id":407,"url":"https:\/\/1usaeh37xc8k42ejdw3evw3c-wpengine.netdna-ssl.com\/wp-content\/uploads\/2017\/10\/shutterstock_504057289.jpg","link":"https:\/\/agfundernews.com\/cultured-meat-will-cost-startups-150m-370m-and-take-at-least-4-more-years-to-bring-to-market.html","title":"Cultured Meat Will Cost Startups $150m-$370m (and Take At Least 4 More","thumbnail":"https:\/\/tse4.mm.bing.net\/th?id=OIP.gMDJPyvPVhGz0PyEvFwyDQHaFj&pid=15.1","size":"4923 x 3692 \u00b7 jpeg","desc":"cultured meat cost","filetype":"jpg","width":4923,"height":3692,"domain":"agfundernews.com","created_at":null,"updated_at":null, LIVEKINDLY","thumbnail":"https:\/\/tse1.mm.bing.net\/th?id=OIP.PuzxAYEuZcTTRYZycAfDswHaEK&pid=15.1","size":"1500 x 844 \u00b7 jpeg","desc":"cultured grist debuts cultivated livekindly folks","filetype":"jpg","width":1500,"height":844,"domain":"www.livekindly.co","created_at":null,"updated_at":null,"id":13742,"keyword_id":407,"url":"http:\/\/dickinsondiamondco.com\/wp-content\/uploads\/2015\/07\/Cultured-Pearls.jpg","link":"http:\/\/dickinsondiamondco.com\/2015\/07\/30\/cultured-pearls\/","title":"Dickinson Diamond Co. ,"id":13743,"keyword_id":407,"url":"https:\/\/wonderfest.org\/wp-content\/uploads\/2019\/03\/CulturedMeat.jpg","link":"https:\/\/wonderfest.org\/cultured-meat-2\/","title":"Cultured Meat \u2013 Oct 27 \u2013 Wonderfest \u2013 Bay Area Beacon of Science","thumbnail":"https:\/\/tse3.mm.bing.net\/th?id=OIP.wMGclgMRpFHKtBYy-Yd-EgHaDt&pid=15.1","size":"800 x 400 \u00b7 jpeg","desc":"cultured wonderfest","filetype":"jpg","width":800,"height":400,"domain":"wonderfest.org","created_at":null,"updated_at":null,"id":13744,"keyword_id":407,"url":"https:\/\/shirtoid.com\/wp-content\/uploads\/2013\/09\/cultured.jpg","link":"https:\/\/shirtoid.com\/99366\/cultured\/","title":"Cultured - Shirtoid","thumbnail":"https:\/\/tse1.mm.bing.net\/th?id=OIP.g-0rryLx7q2ewQq6T3trDAHaHa&pid=15.1","size":"500 x 500 \u00b7 jpeg","desc":"cultured shirtoid shirt woot","filetype":"jpg","width":500,"height":500,"domain":"shirtoid.com","created_at":null,"updated_at":null,"id":13745,"keyword_id":407,"url":"http:\/\/www.thehaasbrothers.com\/hsite\/wp-content\/uploads\/2013\/12\/Cover-Cultured-BASEL-3-780x972.jpg","link":"http:\/\/www.thehaasbrothers.com\/cultured-magazine-4\/?color=2","title":"Cultured * HAAS BROTHERS","thumbnail":"https:\/\/tse4.mm.bing.net\/th?id=OIP.iwmyZ9gQqrEgHcaUTe_1bAHaJO&pid=15.1","size":"780 x 972 \u00b7 jpeg","desc":"","filetype":"jpg","width":780,"height":972,"domain":"www.thehaasbrothers.com","created_at":null,"updated_at":null,"id":13746,"keyword_id":407,"url":"https:\/\/schillings.com\/wp-content\/uploads\/White-cultured-marble-vainity-top-room-scene.jpg","link":"https:\/\/emetdesign.blogspot.com\/2021\/06\/white-cultured-marble-countertops.html","title":"White Cultured Marble Countertops - emetdesign","thumbnail":"https:\/\/tse3.mm.bing.net\/th?id=OIP.dPYMthhZAnuts7zZ9IHXHwHaHa&pid=15.1","size":"1000 x 1000 \u00b7 jpeg","desc":"cultured schillings","filetype":"jpg","width":1000,"height":1000,"domain":"emetdesign.blogspot.com","created_at":null,"updated_at":null,"id":13747,"keyword_id":407,"url":"https:\/\/4.bp.blogspot.com\/-41clmrQFKCE\/TjGn3TcO0II\/AAAAAAAAACc\/IIGhnBCsozc\/s1600\/Creating+Cultured+Meat.jpg","link":"https:\/\/my-environmental-stance.blogspot.com\/2011\/07\/cultured-meat-think-of-possibilities.html","title":"THE HUMAN INFLUENCE: Cultured Meat: Think of the Possibilities","thumbnail":"https:\/\/tse3.mm.bing.net\/th?id=OIP.kyjxqsWhI76ITao_E9GC2AHaFj&pid=15.1","size":"960 x 720 \u00b7 jpeg","desc":"meat cultured cloned production culture possibilities produced meet creating stuff difference between animal influence human works alchetron ethical","filetype":"jpg","width":960,"height":720,"domain":"my-environmental-stance.blogspot.com","created_at":null,"updated_at":null,"id":13748,"keyword_id":407,"url":"https:\/\/stangomj.files.wordpress.com\/2011\/02\/cultured.jpg","link":"https:\/\/stangomj.wordpress.com\/category\/culture\/","title":"Culture ,"id":13749,"keyword_id":407,"url":"http:\/\/www.culturedstoners.com\/wp-content\/uploads\/2013\/01\/Picture-008.jpg","link":"https:\/\/www.culturedstoners.com\/","title":"Cultured Stone - The Cultured Stoners","thumbnail":"https:\/\/tse1.mm.bing.net\/th?id=OIP.2brznd4NrheuFolnXDy9MwHaFj&pid=15.1","size":"2592 x 1944 \u00b7 jpeg","desc":"stone cultured exteriors","filetype":"jpg","width":2592,"height":1944,"domain":"www.culturedstoners.com","created_at":null,"updated_at":null,"id":13750,"keyword_id":407,"url":"http:\/\/lifestylekitchensbaths.com\/wp-content\/uploads\/2015\/01\/cultured-marble-countertops.jpg","link":"https:\/\/lifestylekitchensbaths.com\/products\/countertops\/cultured-marble\/","title":"St. Louis Cultured Marble Countertops , Cultured Decadence secures funding to accelerate","thumbnail":"https:\/\/tse1.mm.bing.net\/th?id=OIP.qqLgHw7nJT7eJtih8z2dTwHaEK&pid=15.1","size":"1600 x 900 \u00b7 jpeg","desc":"decadence secures","filetype":"jpg","width":1600,"height":900,"domain":"www.foodbusinessafrica.com","created_at":null,"updated_at":null,"id":13752,"keyword_id":407,"url":"https:\/\/149353356.v2.pressablecdn.com\/wp-content\/uploads\/2019\/03\/Cultured-meat-graphics_1162809340.jpg","link":"https:\/\/poultry.extension.org\/blog\/","title":"Blog \u2013 Small and backyard poultry","thumbnail":"https:\/\/tse4.mm.bing.net\/th?id=OIP.AqVbIiJQ5hvkyOSkEM7nGgHaE7&pid=15.1","size":"5000 x 3333 \u00b7 jpeg","desc":"cultured viande vitro kultiviertes cell developed usda fad pipette assiettes lilkin depositphotos cellular simplyscience foodsafetynews","filetype":"jpg","width":5000,"height":3333,"domain":"poultry.extension.org","created_at":null,"updated_at":null,"id":13753,"keyword_id":407,"url":"http:\/\/fixr.wpmedia.s3.amazonaws.com\/blog\/wp-content\/uploads\/2010\/03\/cultured_marble_top-1023x767.jpg","link":"http:\/\/www.visualremodeling.com\/2010\/04\/23\/cultured-marble\/","title":"Cultured marble: An Affordable Way to Upgrade ,"id":13754,"keyword_id":407,"url":"https:\/\/pbs.twimg.com\/profile_images\/1128438585\/Cultured_BC_image_400x400.jpg","link":"https:\/\/twitter.com\/CulturedCafeLB","title":"Cultured (@CulturedCafeLB) ,"id":13755,"keyword_id":407,"url":"https:\/\/www.imprint.co.uk\/wp-content\/uploads\/2015\/09\/being-cultured.jpg","link":"https:\/\/www.imprint.co.uk\/product\/being-cultured\/","title":"Being Cultured - Imprint Academic","thumbnail":"https:\/\/tse1.mm.bing.net\/th?id=OIP.PzMLIv0eajNV2rJUvBufUgAAAA&pid=15.1","size":"386 x 600 \u00b7 jpeg","desc":"cultured being imprint defence discrimination academic africanah","filetype":"jpg","width":386,"height":600,"domain":"www.imprint.co.uk","created_at":null,"updated_at":null,"id":13756,"keyword_id":407,"url":"http:\/\/www.culturedstoners.com\/wp-content\/uploads\/2015\/11\/Front-view-light-2.jpg","link":"https:\/\/www.culturedstoners.com\/cultured-stone-fireplaces\/","title":"Cultured Stone Fireplaces - The Cultured Stoners","thumbnail":"https:\/\/tse3.mm.bing.net\/th?id=OIP.bPQGXZ95i-oFqhQkyB8_bgHaLH&pid=15.1","size":"800 x 1200 \u00b7 jpeg","desc":"stone cultured fireplaces fireplace call front","filetype":"jpg","width":800,"height":1200,"domain":"www.culturedstoners.com","created_at":null,"updated_at":null,"id":13757,"keyword_id":407,"url":"https:\/\/i1.wp.com\/www.chocolatesuze.com\/wp-content\/uploads\/2018\/06\/Cured-and-Cultured-Opera-House-Yabbies.jpg?resize=1700%2C1130","link":"https:\/\/www.chocolatesuze.com\/2018\/07\/01\/cured-cultured-bar-bennelong-sydney-opera-house\/","title":"Cured and Cultured Bar @ Bennelong, Sydney Opera House","thumbnail":"https:\/\/tse2.mm.bing.net\/th?id=OIP.IKlCqS5HvdCJ5O_r6NluUQHaE7&pid=15.1","size":"1700 x 1130 \u00b7 jpeg","desc":"bennelong sydney cured cultured opera bar","filetype":"jpg","width":1700,"height":1130,"domain":"www.chocolatesuze.com","created_at":null,"updated_at":null,"id":13758,"keyword_id":407,"url":"https:\/\/www.calcraftedmarble.com\/wp-content\/uploads\/2014\/08\/Square-Cultured-Sink-LOW.jpg","link":"https:\/\/www.calcraftedmarble.com\/products-services\/cultured-products\/?share=twitter","title":"Cultured Marble Onyx & Granite Products San Diego","thumbnail":"https:\/\/tse1.mm.bing.net\/th?id=OIP.sh1EU2OdW7NgBKaaWjzsnAHaJ6&pid=15.1","size":"1935 x 2592 \u00b7 jpeg","desc":"cultured onyx diyhous","filetype":"jpg","width":1935,"height":2592,"domain":"www.calcraftedmarble.com","created_at":null,"updated_at":null,"id":13759,"keyword_id":407,"url":"https:\/\/i.redd.it\/e2f8kyn0e4t01.jpg","link":"https:\/\/www.reddit.com\/r\/therewasanattempt\/comments\/8dqjy1\/to_look_cultured\/","title":"to look cultured : therewasanattempt","thumbnail":"https:\/\/tse1.mm.bing.net\/th?id=OIP.9P7CMArM7St8JaaVg1XHwwHaLH&pid=15.1","size":"1080 x 1620 \u00b7 jpeg","desc":"cultured therewasanattempt","filetype":"jpg","width":1080,"height":1620,"domain":"www.reddit.com","created_at":null,"updated_at":null,"id":13760,"keyword_id":407,"url":"https:\/\/www.culturedfoodlife.com\/wp-content\/uploads\/2013\/10\/orangeade1.jpg","link":"https:\/\/www.culturedfoodlife.com\/recipe\/cultured-vegetables-using-a-starter-culture\/","title":"Cultured Vegetables Using a Starter Culture - Cultured Food Life","thumbnail":"https:\/\/tse2.mm.bing.net\/th?id=OIP.hIMkJuwwo01e_oGr0ywFDgHaFj&pid=15.1","size":"1024 x 768 \u00b7 jpeg","desc":"cultured vegetables culture starter using super donna check orangeade charging cutting edge fermented","filetype":"jpg","width":1024,"height":768,"domain":"www.culturedfoodlife.com","created_at":null,"updated_at":null,"id":13761,"keyword_id":407,"url":"http:\/\/www.thehaasbrothers.com\/hsite\/wp-content\/uploads\/2013\/12\/Cover-Story-Cultured-BASEL-20134-780x972.jpg","link":"http:\/\/www.thehaasbrothers.com\/cultured-magazine-4\/?color=2","title":"Cultured * HAAS BROTHERS","thumbnail":"https:\/\/tse4.mm.bing.net\/th?id=OIP.kpYNvURzxfNBvGuPwlkbYwHaJO&pid=15.1","size":"780 x 972 \u00b7 jpeg","desc":"cultured","filetype":"jpg","width":780,"height":972,"domain":"www.thehaasbrothers.com","created_at":null,"updated_at":null,"id":13762,"keyword_id":407,"url":"https:\/\/i.redd.it\/1fkn86eydo951.jpg","link":"https:\/\/www.reddit.com\/r\/Animemes\/comments\/hnmbhh\/cultured_art\/","title":"Cultured \"art\" : Animemes","thumbnail":"https:\/\/tse3.mm.bing.net\/th?id=OIP.DYLIRLLKI0OOJx39A_HhvAHaLj&pid=15.1","size":"1028 x 1604 \u00b7 jpeg","desc":"cultured animemes","filetype":"jpg","width":1028,"height":1604,"domain":"www.reddit.com","created_at":null,"updated_at":null,"id":13763,"keyword_id":407,"url":"http:\/\/www.thehaasbrothers.com\/hsite\/wp-content\/uploads\/2013\/12\/Cover-Story-Cultured-BASEL-.42-780x972.jpg","link":"http:\/\/www.thehaasbrothers.com\/cultured-magazine-4\/?color=2","title":"Cultured * HAAS BROTHERS","thumbnail":"https:\/\/tse2.mm.bing.net\/th?id=OIP.tt1tyliOkSQIkhxhsNJuawHaJO&pid=15.1","size":"780 x 972 \u00b7 jpeg","desc":"cultured policy","filetype":"jpg","width":780,"height":972,"domain":"www.thehaasbrothers.com","created_at":null,"updated_at":null,"id":13764,"keyword_id":407,"url":"https:\/\/i.pinimg.com\/originals\/91\/4e\/75\/914e75b43d9c19202391b73d06c55227.jpg","link":"https:\/\/clickflydesigns.blogspot.com\/2021\/06\/cultured-marble-shower-base.html","title":"Cultured Marble Shower Base - clickflydesigns","thumbnail":"https:\/\/tse3.mm.bing.net\/th?id=OIP.4s7KS6C91xu3Dt_NEnoGcwHaLH&pid=15.1","size":"3456 x 5184 \u00b7 jpeg","desc":"cultured surround kohler whitewater","filetype":"jpg","width":3456,"height":5184,"domain":"clickflydesigns.blogspot.com","created_at":null,"updated_at":null,"id":13765,"keyword_id":407,"url":"http:\/\/www.virology.ws\/wp-content\/uploads\/2011\/01\/cultured_cells.jpg","link":"http:\/\/www.virology.ws\/2011\/01\/13\/multiplicity-of-infection\/","title":"Multiplicity of infection","thumbnail":"https:\/\/tse3.mm.bing.net\/th?id=OIP.uy94PqWpsdOzi4dardp60gAAAA&pid=15.1","size":"273 x 179 \u00b7 jpeg","desc":"infection multiplicity virus cells cultured virology question week moi matters concentration ws","filetype":"jpg","width":273,"height":179,"domain":"www.virology.ws","created_at":null,"updated_at":null,"id":13766,"keyword_id":407,"url":"https:\/\/c8.alamy.com\/comp\/B6DYNM\/enterobacter-bacteria-enterobacter-colonies-being-cultured-on-an-agargrowth-B6DYNM.jpg","link":"http:\/\/webstreaming.com.br\/what-is-being-cultured.html","title":"\ud83d\ude02 What is being cultured. Cultured Synonyms, Cultured Antonyms. 2019-02-23","thumbnail":"https:\/\/tse1.mm.bing.net\/th?id=OIP.Y-XAi7_3slloyUf17dB-ZwHaFi&pid=15.1","size":"1300 x 972 \u00b7 jpeg","desc":"cultured being enterobacter alamy colonies bacteria petri someone makes","filetype":"jpg","width":1300,"height":972,"domain":"webstreaming.com.br","created_at":null,"updated_at":null,"id":13767,"keyword_id":407,"url":"https:\/\/www.wolfhomeproducts.com\/smugmugimages\/i-FkdGz8d\/0\/O\/i-FkdGz8d-O.jpg","link":"https:\/\/www.wolfhomeproducts.com\/vanitytops\/cultured-marble","title":"Cultured Marble ,"id":13768,"keyword_id":407,"url":"https:\/\/www.bulatlat.com\/wp-content\/uploads\/2015\/06\/Cultured.jpg","link":"https:\/\/www.bulatlat.com\/2015\/06\/24\/cultured\/","title":"Cultured - Bulatlat","thumbnail":"https:\/\/tse3.mm.bing.net\/th?id=OIP.F_lRNihcM8dHxIgLzhYtaAHaDG&pid=15.1","size":"2976 x 1247 \u00b7 jpeg","desc":"cultured bulatlat dee ayroso philippine teens martin culture arts june","filetype":"jpg","width":2976,"height":1247,"domain":"www.bulatlat.com","created_at":null,"updated_at":null, ThriftyFun","thumbnail":"https:\/\/tse2.mm.bing.net\/th?id=OIP.OLNXsS4L1_ruJ9PsKb1DPwHaE6&pid=15.1","size":"1200 x 797 \u00b7 jpeg","desc":"marble cultured cleaning faux sink","filetype":"jpg","width":1200,"height":797,"domain":"www.thriftyfun.com","created_at":null,"updated_at":null] A garden of roses is a spectacular sight to behold, with their brilliant colors and intoxicating fragrance. Roses are also one of the most popular flowers for home landscaping, with many varieties to choose from. One of the best things about this flower is this site you are coming to the right page. Contains many images about Cultured The human influence: cultured meat: think of the possibilities. Don't forget to bookmark this page for future reference or share to facebook / twitter if you like this page.

No comments:
Post a Comment